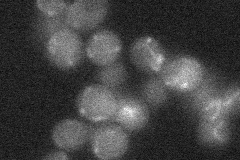
YNL063W
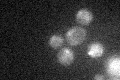
YNL063W

View description
S-adenosylmethionine-dependent methyltransferase; methylates translational release factor Mrf1p; similar to E.coli PrmC; is not an essential gene
Localization:
Intensity:
Fold change:
Significance:
-
C’ GFP library in SD

mitochondria19.69 -
N' NOP1pr-GFP in SD

cytosol,punctate,nucleus30.6932 -
N' TEF2pr-mCherry in SD

ambiguous,vacuole0 -
N' NATIVEpr-GFP in SD
below threshold16.3395 -
N' TEF2pr-VC and Cyto-VN in SD

#N/A0 -
C’ GFP library in SD+DTT

mitochondria13.590.68No -
C’ GFP library in SD+H2O2
mitochondria16.310.82No -
C’ GFP library in Starvation Media

mitochondria16.770.85No -
C’ GFP library on the background of Pup2-DaMP

mitochondria -
C’ GFP library on the background of CCT mutant

mitochondria22.44821.13955No
